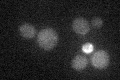
YBR280C
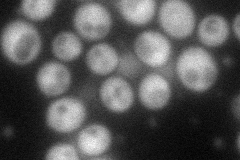
YBR280C
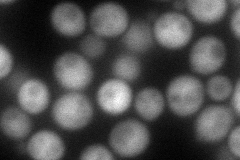
YBR280C
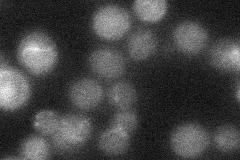
YBR280C
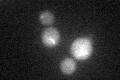
YBR280C
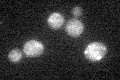
YBR280C
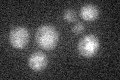
YBR280C

View description
F-Box protein involved in proteasome-dependent degradation of Aah1p during entry of cells into quiescence; interacts with Skp1
Localization:
Intensity:
Fold change:
Significance:
-
C’ GFP library in SD
below threshold17.22 -
N' NOP1pr-GFP in SD
cytosol79.6772 -
N' TEF2pr-mCherry in SD
cytosol94.5632 -
N' NATIVEpr-GFP in SD
below threshold20.8211 -
N' TEF2pr-VC and Cyto-VN in SD

cytosol48.053 -
C’ GFP library in SD+DTT
cytosol17.511.01No -
C’ GFP library in SD+H2O2
cytosol18.441.07No -
C’ GFP library in Starvation Media
cytosol16.570.96No -
C’ GFP library on the background of Pup2-DaMP

below threshold -
C’ GFP library on the background of CCT mutant

below threshold19.31061.12099No
